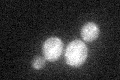
YLR420W
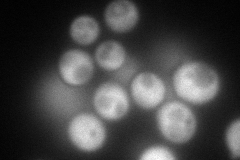
YLR420W
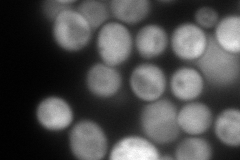
YLR420W
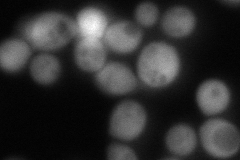
YLR420W
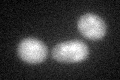
YLR420W
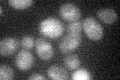
YLR420W

View description
Dihydroorotase, catalyzes the third enzymatic step in the de novo biosynthesis of pyrimidines, converting carbamoyl-L-aspartate into dihydroorotate
Localization:
Intensity:
Fold change:
Significance:
-
C’ GFP library in SD
cytosol22 -
N' NOP1pr-GFP in SD
cytosol183.833 -
N' TEF2pr-mCherry in SD
cytosol239.46 -
N' NATIVEpr-GFP in SD
cytosol178.852 -
N' TEF2pr-VC and Cyto-VN in SD

#N/A0 -
C’ GFP library in SD+DTT
cytosol16.770.76No -
C’ GFP library in SD+H2O2

cytosol19.760.89No -
C’ GFP library in Starvation Media
cytosolN/AN/AYes -
C’ GFP library on the background of Pup2-DaMP

cytosol -
C’ GFP library on the background of CCT mutant

cytosol16.8820.767269No
